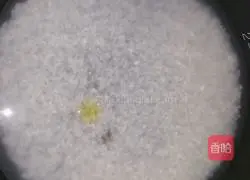
Illustration of how to make tuna kimbap 1

Health benefits
Rice: activate blood circulation and remove blood stasis
Sesame oil: delay aging, antioxidant, anti-cancer and prevent cancer
Ingredients
Rice ( 1 measuring cup ) | Seaweed ( 3 sheets ) |
Cucumber ( 1 root ) | Carrot ( appropriate amount ) |
Eggs ( 1 ) | Tuna ( 1 box ) |
Sushi vinegar ( appropriate amount ) | Olives Oil ( a little ) |
Sesame ( a little ) | Salt ( a little ) |
Salad dressing (appropriate amount) | Sesame oil ( a little ) |
How to make tuna kimbap
1.Wash the rice, put it into a pot, add an appropriate amount of water, add a little olive oil and cook

2.Wash the cucumber and cut it into strips, cut the carrot into strips and salt it with a little salt to remove the water

3.Heat a pan, add a little oil, stir the eggs evenly and pour them into the pan, fry until cooked

4.Cut the egg skin into strips

5. After the rice is cooked, pour a little Mix sushi vinegar, sesame oil and sesame seeds and simmer for 2 minutes

6. Place a piece of nori on the sushi curtain , spread the rice evenly and compact it with a rice spatula, leaving 3 cm on one end without rice for easy rolling

7.Place cucumber sticks, carrot sticks, eggs and tuna on the rice

8.Slowly roll it up with a sushi curtain, roll it tightly and wrap it up

9.Use a knife Cut into small pieces, add a little salad dressing and serve
When cooking rice, add a little olive oil to make the rice more fragrant.Add vinegar while it is hot and mix well.Roll it tightly to avoid unraveling
Copyright Statement:This article is a reprinted article, and the copyright belongs to the original author. Please retain the source when reprinting!







